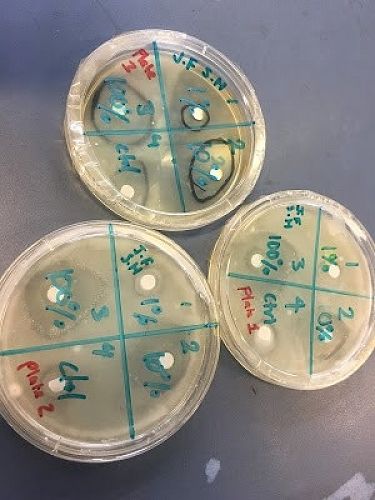

Science 2017
Wow! In my 20 years of teaching Science, never have I seen such a wonderful attitude towards learning from an entire school. I have been so proud to be in the classroom watching our students' thirst for knowledge and understanding.
Dr William Naylor joined our department for the first two terms whilst Ms Helen Boothby was studying the Nature of Science in the New Zealand curriculum. Helen went to Lincoln University and study fossilised rat poo and how rats may have led to the extinction of the moa. Ms Boothby re-joined us in Terms 3 & 4.
A special thank you to Mr Tony Palmer and Ms Alex Aitken, who also joined our department this year and taught our Year 7 and 8 classes. I know all of those students had a great time this year.
There have been so many memorable moments this year, it is so hard to write about all of them as it would require a whole chapter. So here are a few…
Year 7s were exposed to the Project Based Learning being used by the Year 9 and 10s. Instead of focussing on a community project like the Year 9 & 10s, the students in Year 7 were asked to get into groups of 3 and develop a space rescue mission. The scenario was that an astronaut had been left on Mars and needed to be rescued. It was going to be a 300 day mission in which they would have to battle against a number of challenges. All students had 7 checkpoints that they were expected to meet along the way. The checkpoints ranged from practical drawing and design of the spaceship to action plans. The concept was based around the movie 'The Martian ' with some exerts being used to discuss issues in space travel. The groups had 3 weeks to complete the project and all groups managed to do this well. Not only was it great learning but all the students applied themselves to the task.
Year 10 students had a lot of fun shooting off bottle rockets, wiring a house, studying earthquakes, measuring the speed of cars along Waterloo Road and doing some very interesting experiments with Mr Minto. I was really proud when some of the Year 10 girls even wanted to help out with the Year 7 classes to make bird feeders.
In Year 11 this year, the students had half a year of practical work. There were three major investigations and plenty of other minor experiments. The Physics investigation was on bending light and how that affected how mirages formed and why diamonds sparkled. The Chemistry investigation was on how different chemicals reacted with each other. The Biology investigation looked at how effective antiseptics were at killing bacteria. I was blown away by the hard work every single student in Year 11 put into their studies this year. Many students came into the Science labs during intervals and lunchtimes to get extra assistance in preparation for their examinations.
Well done Hornby High School! You have had a brilliant year.
Matt Stock
Head of Science
Gallery